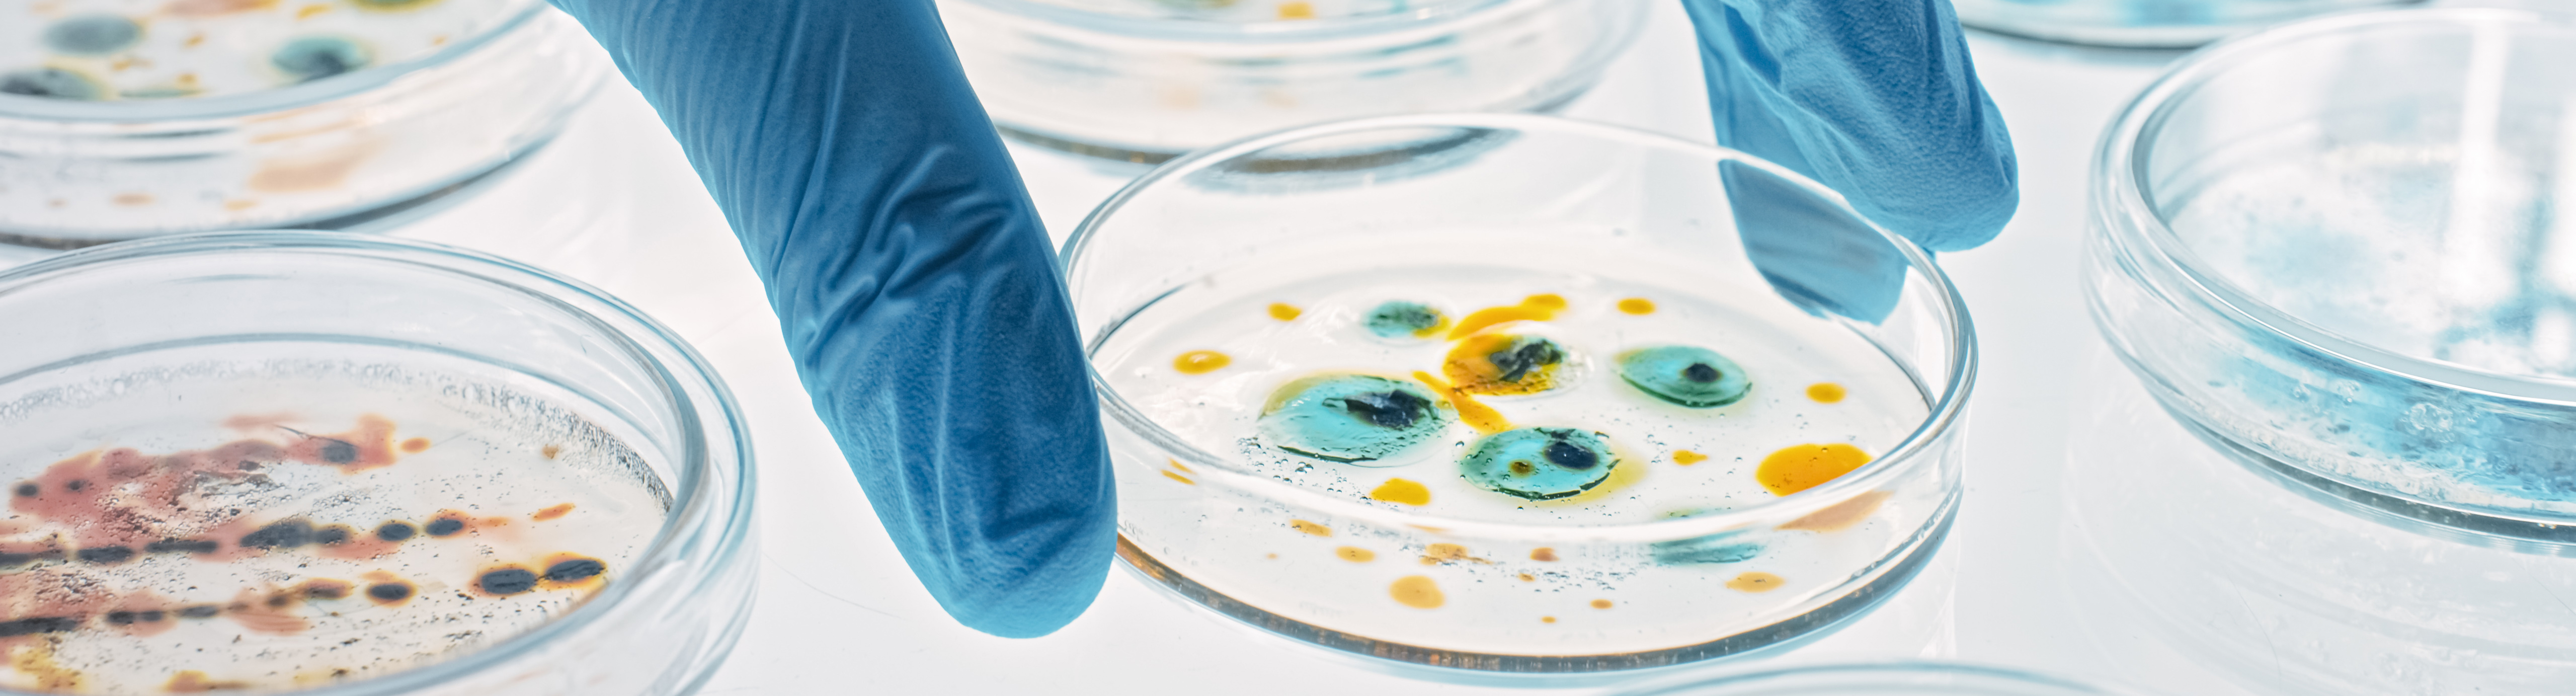
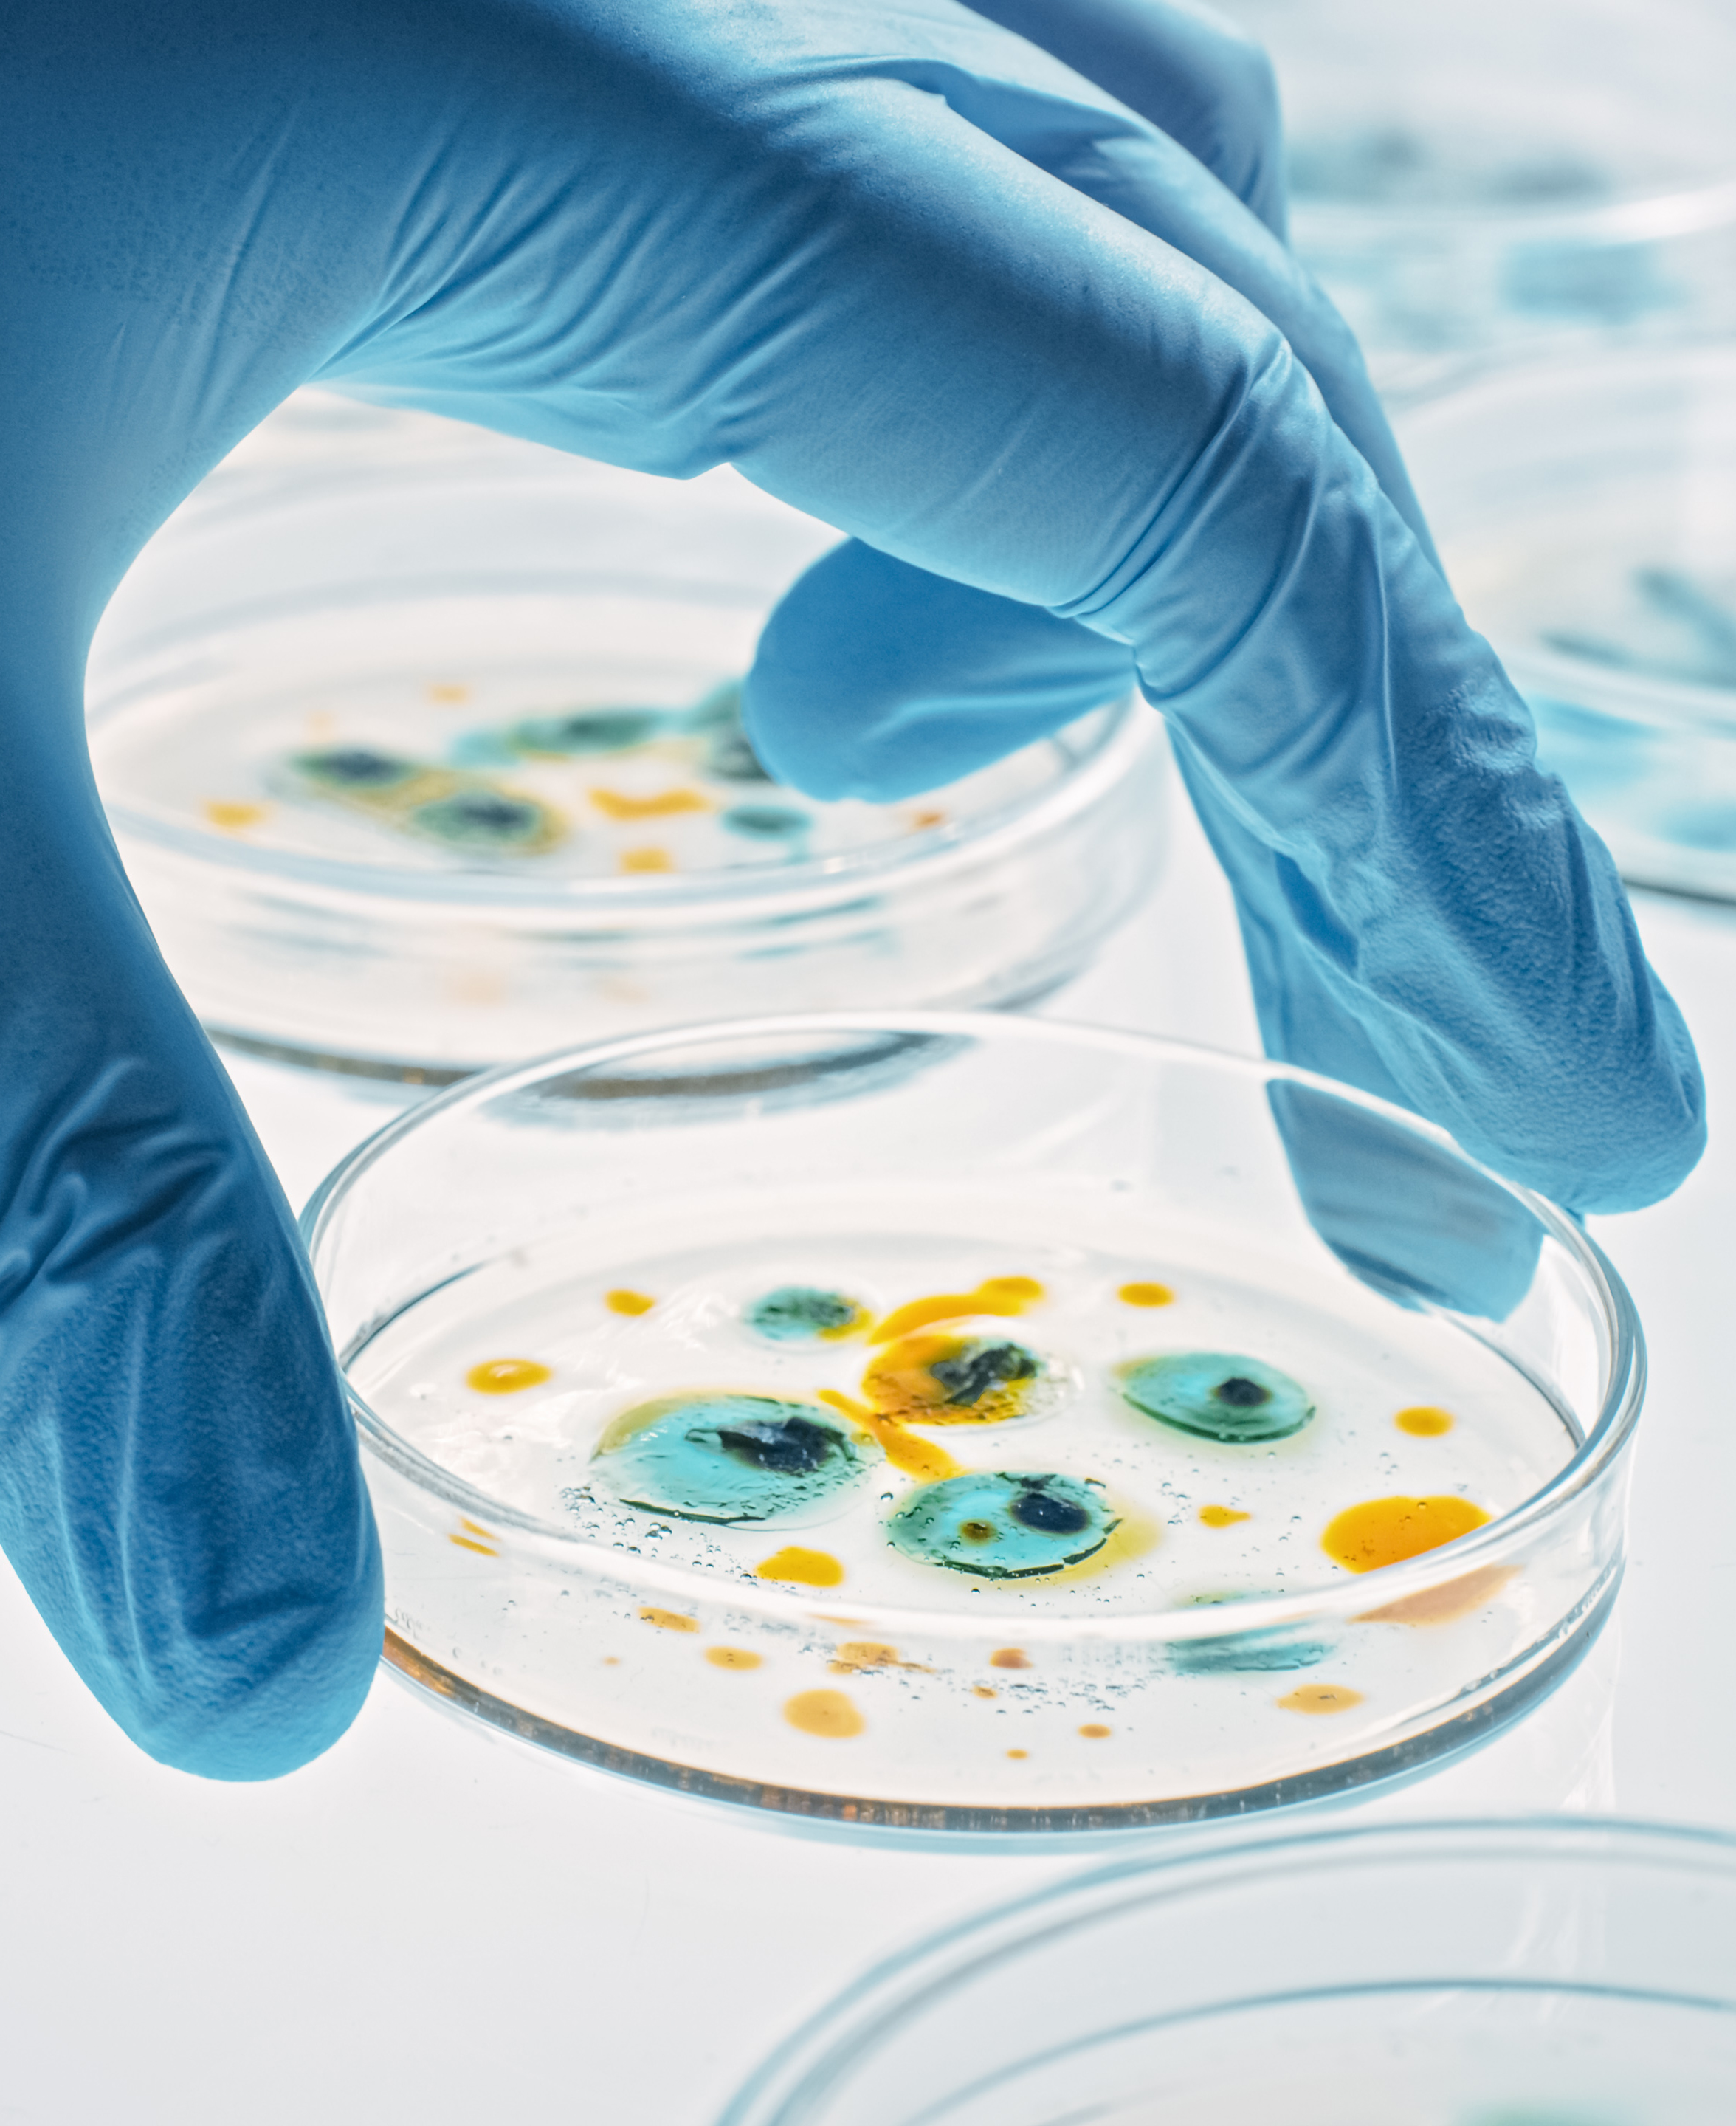

-
Con el cambio de milenio llegaba un nuevo concepto que hacía referencia a la interconexión digital entre objetos del mundo físico e Internet. Era el llamado Internet de las cosas (IoT) y, según los cálculos de la empresa estadounidense Cisco, en 2025 habrá 75 billones de dispositivos conectados. Por ello, la capacidad de recogida de datos se multiplica y posibilita, si se analizan correctamente, obtener patrones individuales a nivel masivo. Es el Internet of Behaviour (IoB) o Internet del Comportamiento.
Los humanos tenemos capacidades físicas limitadas que pueden ser potenciadas gracias a la tecnología. Los exoesqueletos son estructuras que se pueden “vestir” y que sirven de apoyo y asistencia para los movimientos, o para aumentar las capacidades del cuerpo humano.
-
Facebook Qué son los exoesqueletos y cómo pueden ayudarnos a superar nuestras limitaciones humanas
-
Twitter Qué son los exoesqueletos y cómo pueden ayudarnos a superar nuestras limitaciones humanas
-
Linkedin Qué son los exoesqueletos y cómo pueden ayudarnos a superar nuestras limitaciones humanas
-
Whatsapp
-
-
El movimiento no code o low code es una filosofía digital que permite a cualquier persona crear aplicaciones y programas sin necesidad de saber programación. Es lo que se conoce como “programación sin código” o “programación visual”. Es decir, un desarrollo que prescinde de lenguajes de codificación para que la creación sea un proceso más sencillo e intuitivo.
Cortar y pegar genes es la base de CRISPR, la técnica de edición genética que, descubierta hace un lustro, ya está dando sus primeros frutos en el tratamiento y diagnóstico de varias enfermedades y dolencias. Te explicamos qué es esta tecnología y para qué se utiliza.
-
Según la Organización Mundial de la Salud (OMS), en el año 2050 se producirán más muertes relacionadas con las superbacterias que por el cáncer y estas serán la principal causa de muerte en el planeta. Y, cuando se publicó este estudio , la institución no había tenido en cuenta el acelerón que iba a provocar el consumo excesivo e incorrecto de antibióticos provocado por la pandemia de covid.
Ya conocemos a las empresas ganadoras del NewTech Challenge lanzado por Vineyard Wind, compañía participada en un 50 % por el grupo Iberdrola a través de su filial AVANGRID. SICdrone, Night Vision Technology Solutions y Open Ocean Robotics desarrollarán un proyecto piloto, de la mano de Vineyard Wind y Greentown Labs, con el objetivo de buscar tecnología que minimice el impacto de la instalación de parques eólicos marinos en los mamíferos de la zona. A continuación, entrevistamos a estas start-ups para saber un poco más sobre su creación, sus propósitos y sus proyectos.
-
Facebook Conoce a los ganadores del Offshore Wind Challenge, una aceleradora de 'start-ups' para proteger a los mamíferos marinos
-
Twitter Conoce a los ganadores del Offshore Wind Challenge, una aceleradora de 'start-ups' para proteger a los mamíferos marinos
-
Linkedin Conoce a los ganadores del Offshore Wind Challenge, una aceleradora de 'start-ups' para proteger a los mamíferos marinos
-
Whatsapp
-